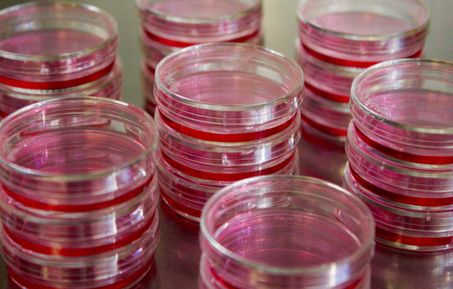

Decoding the molecular cross-talk between blood stem cells and their niches, its role in the maintenance of homeostasis, regeneration and the development of haematological malignancies.
Find out more
Join the team!
We welcome informal inquires about opportunities to join the lab. Get in touch!
We welcome researchers from all over the world. If you need to apply for a Visa, our Human Resources team will provide all the support needed to guide you through the process.